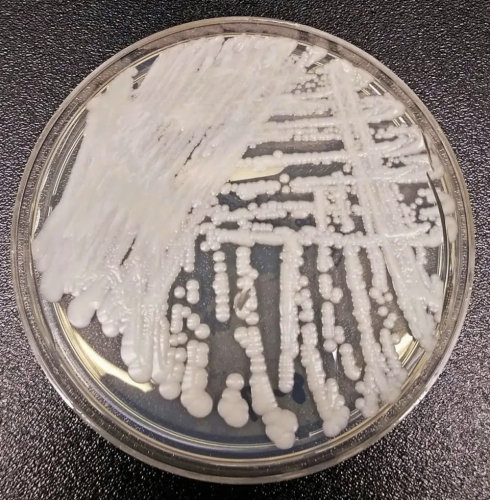
Anvisa confirma segundo caso do fungo Candida auris em Pernambuco

Casos de coronavírus na Paraíba em 14 de janeiro de 2022
Paraíba tem 467.443 casos confirmados e 9.614 mortes por coronavírus. São 504 novos casos registrados no boletim desta sexta (14) e uma morte notificada. Paraíba tem 467.443 casos confirmados de contaminação pelo novo coronavírus
Divulgação/Ascom
A Paraíba tem 467.443 casos confirmados de contaminação pelo novo coronavírus, segundo informações da Secretaria de Estado da Saúde (SES). O número de...
Governadora do RN anuncia concurso da Polícia Militar para a área da saúde
Serão disponibilizadas 78 vagas para Oficiais. Inscrições começam na terça-feira (18). Governadora Fátima Bezerra anuncia concurso da Polícia Militar para a área da saúde
Elisa Elsie
A governadora do Rio Grande do Norte, Fátima Bezerra, anunciou nesta sexta-feira (14) a realização de concurso para Oficiais da Polícia Militar que atuarão na área da saúde. Serão oferecidas 78 vagas.
O...
TJ-SP triplica limite de auxílio-saúde de magistrados
O Tribunal de Justiça de São Paulo (TJ-SP) aumentou nesta semana a possibilidade de reembolso mensal de auxílio-saúde dos magistrados do órgão, de 3% para até 10% dos salários. Dessa forma, o limite para os desembargadores, que antes era de pouco mais de R$1.063, passou a ser de pouco mais de R$ 3.546. Para os servidores, o aumento foi...
Incêndio atinge sucata na Zona Oeste de Natal
Fogo atingiu localidade na tarde desta sexta-feira (14). Fogo atingiu a sucata em Felipe Camarão, em Natal, RN
Sérgio Henrique Santos/Inter TV Cabugi
Um incêndio atingiu uma sucata na tarde desta sexta-feira (14) no bairro Felipe Camarão, na Zona Oeste de Natal. Ninguém ficou ferido.
O depósito fica na Avenida Presidente Ranieri Mazzilli, trecho urbano da BR-226. De acordo...
Moraes determina que PF ouça pessoas que tiveram contato com Roberto Jefferson no hospital
O ministro do Supremo Tribunal Federal (STF) Alexandre de Moraes determinou nesta sexta-feira, 14, que a Polícia Federal ouça pessoas que estiveram com Roberto Jefferson quando ele gravou um vídeo em que disse “orar em desfavor de Xandão”. Na ocasião, o ex-presidente do PTB estava internado no Hospital Samaritano Barra, onde passou por um cateterismo. Moraes atendeu pedido da...
Maioria dos governadores decide descongelar ICMS dos combustíveis
A maioria dos governadores decidiu descongelar o ICMS dos combustíveis. A medida foi adotada em outubro do ano passado, em resposta às críticas do presidente Jair Bolsonaro aos gestores estaduais, e vai vigorar até o dia 31 de janeiro. A decisão foi confirmada à Jovem Pan por assessores do governador do Piauí, Wellington Dias (PT), coordenador do Fórum Nacional...
Kanye West é flagrado em suposta agressão a fã que pedia autógrafo; assista
O departamento da polícia de Los Angeles aponta o rapper Kanye West, ex-marido de Kim Kardashian, como principal suspeito em caso de agressão a um homem nas ruas da cidade. Segundo o site americano TMZ, o episódio teria acontecido após o artista ser parado na rua pela vítima, que se aproximou em busca de um autógrafo. Com a recusa...
Queiroga diz que Doria faz palanque com vacinas do governo: ‘Paulistas merecem alguém melhor’
O ministro da Saúde, Marcelo Queiroga, utilizou as redes sociais, nesta sexta-feira, 14, para atacar o governador de São Paulo, João Doria (PSDB). Mais cedo, o tucano iniciou a imunização de crianças de 5 a 11 anos no país – o indígena Davi Seremrámiwe, de 8 anos, da etnia Xavante, foi o primeiro brasileiro a receber a vacina da...
Suspeito de estuprar idosa no interior do RN é preso na Grande Natal
Crime aconteceu em 2019 no município de Ielmo Marinho. O homem de 25 anos confessou o crime aos policiais que cumpriram o mandado de prisão contra ele. A Polícia Civil prendeu nesta sexta-feira (14) um homem de 25 anos de idade suspeito de estuprar uma idosa no município de Ielmo Marinho, no interior do Rio...
AO VIVO: Conheça os participantes do ‘BBB 22’; médica de Goiás e ator de Santa Catarina são anunciados
A espera finalmente acabou e nesta sexta-feira, 14, o público vai poder conhecer oficialmente os participantes do “BBB 22”. O reality show da Globo estreia na próxima segunda-feira, 17, e mais uma vez vai misturar na casa mais vigiada do Brasil famosos, que integram o grupo “Camarote”, e anônimos, que fazem parte do grupo “Pipoca”. Uma das novidades desta...
Dose de reforço da Janssen reduz hospitalizações por variante Ômicron em 85%, diz estudo
Um estudo feito pelo Conselho de Pesquisa Médica da África do Sul e divulgado nesta sexta-feira, 14, em parceria com a Johnson & Johnson mostra que a dose de reforço da vacina Janssen, desenvolvida pela farmacêutica norte-americana, tem eficácia de 85% contra hospitalizações de infecções causadas pela variante Ômicron do novo coronavírus em um prazo de entre 1 e...
Concurso do Itep: acordo entre MP e governo do RN garante correção de mais provas discursivas
Termo de ajustamento de conduta foi celebrado pelo Ministério Público com o governo do RN e o Instituto AOCP, responsável pela condução do certame. Concurso do Itep-RN: acordo garante correção de mais provas discursivas
Divulgação
O concurso público do Instituto Técnico-Científico de Perícia do Estado (Itep-RN) terá a correção de um número maior de provas discursivas. A retificação...
Enquanto a Covid-19 avança no Brasil, o governo fica de braços cruzados
Ou o governo age rápido, ou teremos de enfrentar novamente um colapso na rede hospitalar do país. Aliás, o governo já demorou demais, como sempre. O número de infectados pela Covid aumenta de maneira assustadora e começa a ficar muito difícil dar atendimento aos infectados pelos vírus. Tudo complicou com a chegada da variante Ômicron. O ministro da Saúde,...
‘Não vejo nenhuma incoerência’, diz Mauro Beting sobre convocação da seleção brasileira
Na manhã da última quinta-feira, 13, o técnico Tite anunciou a lista de 26 convocados para defender a seleção brasileira nos jogos contra o Equador e o Paraguai, válidos pelas Eliminatórias da Copa do Mundo 2022. A lista contou com nomes pedidos pela torcida, como Vinícius Jr. (Real Madrid) e com ausências esperadas, como a de Neymar (PSG), que...
Com Covid-19, Aline Campos é alvo de críticas após procurar por manicure infectada
Isolada em Fernando de Noronha após contrair Covid-19, a modelo Aline Campos, que antes era Aline Riscado, causou polêmica nas redes sociais ao postar um vídeo procurando por serviços de uma manicure que também estivesse infectada. A atriz se pronunciou sobre as críticas e afirmou que segue todos os protocolos de segurança contra a doença. “Estou isolada em Noronha....
Lei transforma moinho de vento de Macau em patrimônio do RN
Estrutura fica localizada na entrada da cidade da Costa Branca potiguar e simboliza a produção de sal na região. Moinho na entrada de Macau, na região da Costa Branca potiguar (Arquivo)
Igor Jácome/G1
O Moinho de Vento de Macau se tornou patrimônio imaterial, histórico, cultural, paisagístico e turístico do Rio Grande do Norte, segundo uma nova lei...
Raio atinge árvore e casa na zona rural de Lagoa Nova, no RN
Chovia e ventava forte no momento do acidente. Duas pessoas estavam na casa, mas ninguém se feriu. Raio atingiu árvore e destelhou parcialmente uma casa na zona rural de Lagoa Nova, no interior do RN
Cedida
Um raio atingiu uma árvore e também parte de uma casa na zona rural da cidade de Lagoa Nova, na região...
Indígena de 8 anos é a primeira criança vacinada contra Covid-19 no Brasil
O Estado de São Paulo vacinou a primeira criança contra a Covid-19 nesta sexta-feira, 14. A imunização aconteceu durante ato simbólico do governo estadual, realizado no Hospital das Clínicas, e contou com a presença do governador João Doria (PSDB). O tucano é o pré-candidato do partido à Presidência da República. O primeiro vacinado foi o indígena Davi Seremrámiwe Xavante,...
Governo britânico pede desculpas à Rainha Elizabeth por festas durante luto por príncipe Philip
O governo do Reino Unido pediu nesta sexta-feira, 14, desculpas formais à rainha Elizabeth II por duas festas realizadas em sua sede no dia 16 de abril, véspera do funeral do príncipe Philip e quando o país estava em luto oficial, informou um porta-voz de Downing Street. Os eventos, nos quais o primeiro-ministro Boris Johnson não esteve presente, segundo...
Ministério da Saúde antecipa a chegada de mais 1,2 milhão de doses pediátricas da Pfizer
O Secretário Executivo do Ministério da Saúde, Rodrigo Cruz, anunciou nesta sexta-feira, 14, que a antecipação da segunda remessa de doses pediátricas da vacina da Pfizer contra a Covid-19, que estava prevista para ser entregue no dia 20 de janeiro. Com isso, o lote de 1,2 milhão de unidades chegará ao Brasil neste domingo, 16. No dia 27, o...
Em 14 dias, janeiro supera número de casos de Covid registrados no mês de dezembro no RN
Mais de mil casos foram registrados somente em um dia. Alta não se reflete na demanda por leitos de UTI e nas mortes por covid-19. Teste Covid-19
Bruno Concha
Em menos de 15 dias, janeiro de 2022 superou o número de casos de covid-19 confirmados pela Secretaria Estadual de Saúde do Rio Grande do Norte (Sesap) ao...
‘Perdi amizades, fãs, contratos e prestígio’, diz Projota sobre participação no ‘BBB 21’
Dias antes de completar um ano de seu anuncio no elenco do ‘BBB 21‘, o rapper Projota falou sobre o impacto do reality para sua carreira. Em entrevista ao jornal O Globo, o artista disse que as confusões em que se envolveu na casa fizeram ele perder “amizades, fãs e contratos” profissionais. Apesar das perdas, o rapper disse que...
Médico do INSS é condenado a mais de 7 anos de prisão e perda do cargo público por estelionato no RN
A denúncia partiu do Ministério Público Federal que também pede a condenação do acusado pelo crime de peculato eletrônico. Agência da Previdência Social; INSS
Divulgação
Um médico perito do Instituto Nacional do Seguro Social (INSS) acusado de fraude, foi condenado a mais de 7 anos de prisão pelo crime de estelionato. Segundo a denúncia do Ministério Público...
RN recebe primeiras doses para crianças e vacinação do público contra a Covid deve começar neste sábado (15), diz Sesap
Após atraso, carregamento chegou ao estado por volta das 10h40 desta sexta-feira (14). Doses de vacinas contra covid-19 para crianças de 5 a 11 anos chegam ao RN
Divulgação
Após um atraso de quase 9 horas, as primeiras doses de vacinas contra Covid-19 voltadas para crianças com idades entre 5 e 11 anos de idade chegaram ao Rio...
Vendas no varejo crescem 0,6% em novembro com Black Friday mais fraca
As vendas no varejo avançaram 0,6% em novembro na comparação com outubro com uma temporada de Black Friday mais fraco e com a maior parte dos segmentos registrando resultado negativo, informou o Instituto Brasileiro de Geografia e Estatística (IBGE) nesta sexta-feira, 14. Entre janeiro e novembro, o comércio teve crescimento de 1,9%, mesma taxa no acumulado em 12 meses....
Alphonso Davies é diagnosticado com miocardite e é afastado do Bayern de Munique
O lateral-esquerdo Alphonso Davies, do Bayern de Munique, foi diagnosticado com sinais leve de miocardite em testes realizados pelo clube na quinta-feira, 13. A informação foi anunciada pelo comandante da equipe, Julian Nagelsmann, em entrevista coletiva realizada nesta sexta-feira, 14. O atleta canadense foi um dos infectados pelo coronavírus e só apresentou os sinais de miocardite após a infecção....
‘Falta de estrutura do setor elétrico pune os consumidores’, diz deputado sobre taxa na conta de luz
O deputado federal Zé Vitor (PL-MG) acionou o Ministério Público Federal (MPF) para que a cobrança da Taxa de Escassez Hídrica, calculada em R$14,20 a cada 100 kWh consumidos, seja revista. A nova bandeira tarifária foi implantada em setembro de 2021 em virtude da crise hídrica atingiu o Brasil. Mesmo após as fortes chuvas que atingiram várias regiões nos...
Presidente da Assembleia Legislativa do RN afirma que está infectado com Covid-19 e gripe ao mesmo tempo
Ezequiel Ferreira postou imagem do resultado positivo para os vírus, disse que está bem e isolado em casa. Ezequiel Ferreira, deputado estadual e presidente da Assembleia Legislativa do RN
Divulgação/ALRN
Após realizar exames laboratoriais, o presidente da Assembleia Legislativa do Rio Grande do Norte (ALRN), deputado Ezequiel Ferreira de Souza (PSDB) confirmou que está infectado ao mesmo tempo...
Embaixada dos Estados Unidos em Bagdá é atacada por quatro mísseis
A embaixada dos Estados Unidos (EUA) em Bagdá, no Iraque, foi atacada por ao menos quatro mísseis nesta quinta-feira, 13. Imagens divulgadas nas redes sociais mostram pontos vermelhos cruzando o céu da capital, enquanto o sistema de defesa do local, responsável por detectar e destruir foguetes, tentava proteger a embaixada. Duas pessoas ficaram feridas, sendo uma mulher e uma...
Polícia Civil da PB vai enviar equipes ao RN para ajudar na investigação de morte de agente em assalto
Polícia lamentou morte do agente identificado como Sandro Roberto Bezerra, de 54 anos, e informou que será uma perda irreparável para a instituição. Sandro Roberto era Policial Civil na Paraíba e foi assassinado na noite dessa quinta (13), na praia de Zumbi, no litoral Norte Potiguar.
Reprodução
A Polícia Civil da Paraíba vai enviar agentes paraibanos para o...
Vacina brasileira contra Covid-19 começa a ser testada em voluntários
Chamada de RNA MCTI CIMATEC HDT, a nova vacina brasileira contra a Covid-19 usa a mesma tecnologia da Pfizer, de RNA mensageiro. O desenvolvimento clínico do imunizante tem a participação de empresas dos Estados Unidos e Índia, além do Brasil. Por aqui, quem está à frente dos estudos é o SENAI Cimatec, que fica em Salvador. A pesquisa tem...
Congestionamento no maior porto da China aumenta e pode impactar agronegócio
Navios que querem evitar atrasos por conta da política de tolerância zero para a Covid-19 na China estão mudando a rota e indo direto para Xangai, o que faz crescer o congestionamento no maior porto de contêineres do mundo, de acordo com informações da Bloomberg. O país asiático tenta conter a disseminação do coronavírus com aumento de restrições à...
Nunes amplia horários de AMAs para atender pacientes com sintomas respiratórios em SP
O prefeito de São Paulo, Ricardo Nunes (MDB), anunciou nesta quinta-feira, 13, a ampliação do horário de funcionamento de 80. Assistências Médicas Ambulatoriais (AMAs) para atender a alta demanda de pacientes com sintomas respiratórios de gripe e Covid-19. Grande parte das unidades passará trabalhar até às 22 horas da noite e uma outra parte ficará aberta 24 horas. O...
Em meio a ameaças de greve, Onyx critica pressão de auditores fiscais por reajuste salarial
O ministro do Trabalho e Previdência, Onyx Lorenzoni, entende que as mobilizações feitas por auditores fiscais, com paralisação marcada para a próxima terça-feira, 18, e ameaça de greve geral em fevereiro é uma “falta de sensibilidade” com a situação do país. Em entrevista ao Jornal da Manhã, da Jovem Pan News, o ministro criticou a pressão do que chamou...
Suspensão da temporada de cruzeiros é prorrogada até o dia 4 de fevereiro
A Associação Brasileira de Navios de Cruzeiros (CLIA Brasil) anunciou a extensão da paralisação da temporada de 2022. No início do mês, houve acordo pela suspensão das atividades até 21 de janeiro. No entanto, com o avanço da variante Ômicron, medida segue até 4 de fevereiro. Mesmo com a suspensão, a CLIA Brasil defende que outras alternativas poderiam ser...
Entenda por que os contestados Coutinho e Daniel Alves estão em alta com Tite
Tite fez a primeira convocação da seleção brasileira em 2022 nesta quinta-feira, 13, e alguns nomes não agradaram os torcedores. Entre eles, Philippe Coutinho – que está há meses sem atuar regularmente por nenhum clube – e Daniel Alves – que retornou recentemente ao Barcelona. Durante a coletiva de imprensa pós-convocação, o treinador explicou por que Coutinho está em...
‘BBB 22’: O que já se sabe sobre a nova edição do reality
Com estreia agendada para a próxima segunda-feira, 17, a 22ª edição do Big Brother Brasil chega repleta de experimentações inéditas. Com método de recrutamento readaptado desde a 20ª temporada, o reality divulgará os participantes durante os intervalos da programação da Rede Globo nesta sexta-feira, 14, provavelmente entre 14h40 e 22h. No grupo Camarote, conhecido por reunir artistas e influenciadores...
Em uma semana, número de testes positivos para Covid-19 em farmácias supera o mês de dezembro
Em apenas uma semana, o número de testes positivos para Covid-19 em farmácias já superou todo o mês de dezembro. Os dados são da Associação Brasileira de Redes de Farmácias e Drogarias (Abramed). Entre 3 e 9 de janeiro, 145.673 pessoas foram infectadas. O volume é 54% o maior que o da semana anterior. O total de atendimento foi...
Reunião entre auditores da Receita e Paulo Guedes termina sem acordo: ‘Frustrante’
A reunião entre os auditores fiscais da Receita Federal e o ministro da Economia, Paulo Guedes, terminou sem acordo. Entre a categoria, uma das reivindicações é a regulamentação do chamado bônus de eficiência, criado em 2016 e que ainda não foi regularizado. O pagamento do benefício custaria cerca de R$ 400 milhões ao governo. No entanto, o presidente do...
Gilmar Mendes é escolhido relator de ação sobre apagão de dados do Ministério da Saúde
O ministro Gilmar Mendes do Supremo Tribunal Federal (STF), foi definido como relator da petição apresentada por deputados do Partido dos Trabalhadores (PT) contra o ministro da Saúde, Marcelo Queiroga. Os parlamentares querem explicações sobre o apagão de dados do ministério. Segundo os petistas, a persistência da falta de dados prejudica a sociedade brasileira como um todo, dificultando as...
Anvisa e Butantan alinham últimas pendências para uso da CoronaVac em crianças
A Agência Nacional de Vigilância Sanitária (Anvisa) e o Instituto Butantan realizaram uma reunião para tratar sobre as últimas pendências para análise do pedido de uso da vacina CoronaVac em crianças e adolescentes de 3 a 17 anos. Segundo a agência reguladora, a avaliação entra na sua etapa final e está próxima da decisão. O encontro online contou com...
Líder de grupo de extrema-direita é preso nos Estados Unidos por ataque ao Capitólio
O líder da organização de extrema-direita Oath Keepers, dos Estados Unidos, foi preso nesta quinta-feira, 13, após ser acusado de conspiração e participação no ataque ao Capitólio, sede do Congresso. Segundo o Departamento de Justiça, Elmer Stewart Rhodes III, de 56 anos, considerado o fundador e líder da organização, foi preso na cidade texana de Little Elm. Essa é...
‘Baby Shark’ é o primeiro vídeo do Youtube a atingir 10 bilhões de visualizações
Vídeos infantis fazem muito sucesso no Youtube, principalmente os de músicas para bebês ou crianças pequenas. E por isso, um deles quebrou o recorde de visualizações na plataforma, que pertencia ao hit ‘Gangnam Style‘, de Psy, de 2012. ‘Baby Shark‘ é hoje o vídeo com maior número de visualizações: 10 bilhões ao todo. O concorrente foi o primeiro a...
Anvisa confirma segundo caso do fungo Candida auris em Pernambuco
A Agência Nacional de Vigilância Sanitária (Anvisa) recebeu a confirmação do segundo caso de Candida auris no país. O “superfungo” foi detectado em um paciente de um hospital em Pernambuco. É o segundo caso confirmado. Os dois pacientes, um homem de 38 anos e uma mulher de 70 anos, foram isolados no início do mês. No dia 3 de janeiro,...
Confira todos os confrontos da terceira fase da Copinha
A terceira fase da Copa São Paulo de Futebol Júnior, a Copinha, começa nesta sexta-feira, dia 14. Ao todo serão 16 jogos entre a sexta e o sábado, com o chaveamento posterior já definido. A partida que abre a terceira fase é Taubaté e Botafogo, às 11h (horário de Brasília). O jogo será disputado em Taubaté. O vencedor dessa...
Copinha: São Paulo vence o EC São Bernardo e enfrenta o São Caetano na próxima fase
O São Paulo é mais um time grande da cidade a avançar de fase na Copinha. Nesta quinta-feira, 13, a equipe comandada por Alex fez 3 a 0 no EC São Bernardo, em São Caetano do Sul, na segunda fase do torneio. A partida foi dominada desde o início pelo Tricolor Paulista. Logo aos dois minutos, Maioli fez tabela...
Inflação acelera na Argentina e fecha 2021 em 50,9%
O índice de preços ao consumidor na Argentina se acelerou em dezembro, quando registrou 3,8% de aumento, fechando o ano de 2021 em 50,9%, uma das taxas de inflação mais altas do mundo, segundo dados divulgados nesta quinta, 13, pelo Instituto de Estadísticas, órgão oficial do governo. No ano, o preço dos alimentos aumentou 50,3%. Os maiores índices foram...
Governador da Califórnia rejeita liberdade condicional para assassino de Robert F. Kennedy
O governador da Califórnia, Gavin Newsom, rejeitou o pedido de liberdade condicional para o assassino de Robert F. Kennedy em 1968, nos Estados Unidos. Sirhan Sirhan está preso desde o crime. “O assassinato do senador Kennedy pelo Sr. Sirhan está entre os crimes mais notórios da história americana”, declarou Newsom em editorial da LA Times na quarta-feira. “Depois de...
Luciano Hang critica Twitter após ser suspenso da rede social: ‘Censura’
O empresário Luciano Hang, dono da rede de lojas Havan, criticou nesta quinta, 13, a rede social Twitter após ter sua conta suspensa por denúncias de compartilhamento de notícias falsas. Hang compartilhou um vídeo do médico Dr. José Augusto Nasser contra a vacinação de crianças contra a Covid-19, que a rede social considerou como enganoso e que transmitia informações...